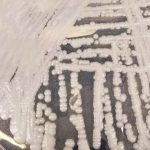

Elon Musk a perdu 100 milliards de dollars en moins d’un an
La fortune d’Elon Musk, qui a dépassé les 300 milliards de dollars en novembre 2021, est aujourd’hui estimée à 210 milliards de dollars.

La fortune d’Elon Musk, qui a dépassé les 300 milliards de dollars en novembre 2021, est aujourd’hui estimée à 210 milliards de dollars.

Selon la règle du nombre de Dunbar, le nombre maximum d’individus avec lequel un être humain peut simultanément entretenir une relation stable est limité à 150.

En Arizona, un Crotale diamantin de l’Ouest a réussi à survivre pendant deux ans sous un hangar sans aucune source d’eau ou de nourriture.

Les fouilles d’un ancien cimetière situé à la périphérie de la ville de Köping, dans le sud de la Suède, ont conduit à la mise au jour de deux armes datant de l’ère viking, enfoncées verticalement dans le sol.

Testez vos connaissances sur la Seconde Guerre mondiale et découvrez si vous êtes un historien dans l’âme !

Plongez dans l’univers Star Wars avec ce superbe support pour votre Echo Dot 4e génération.

Voici 10 faits fascinants sur le Sphinx, l’un des monuments les plus emblématiques du monde. Cette créature légendaire demeure bien mystérieuse.

De nombreux effets quantiques ne peuvent être obtenus qu’à des températures extrêmement basses, ce qui limite leur exploitation dans le monde réel. Aujourd’hui, des chercheurs américains ont démontré que l’un d’entre eux se produisait dans un matériau à température ambiante.

Vous avez très probablement déjà bu un verre de Coca-Cola. Mais saviez-vous que jusqu’en 1903 cette célèbre boisson pétillante contenait également de la cocaïne ?

Au sein du corps médical, les femmes médecins, infirmières ou encore stagiaires sont souvent victimes de sexisme. Dans cette vidéo, elles prennent la parole.

Comment les astronautes produiront-ils des médicaments lors de missions dans l’espace lointain ? Un programme de la NASA se penche sérieusement sur la question.

Le film Hercule va s’inspirer du réseau social TikTok.

Si le requin est principalement connu pour être un redoutable prédateur, il est important de noter qu’il possède également une grande capacité de survie.

Outre les destructions, les décès et les blessures directement causés par les explosions, les deux villes ont également été gangrénées par les radiations.
L’OMS a publié sa toute première liste des champignons qui provoquent des infections fongiques invasives.

Si les montres GPS et les horloges atomiques offrent aujourd’hui une mesure ultraprécise du temps, leur principe de fonctionnement fondamental est le même que celui du cadran solaire, apparu il y a plus de 5 000 ans. Des scientifiques suédois et estoniens ont récemment dévoilé une approche entièrement nouvelle, exploitant des « bizzareries quantiques ».

Un groupe d’animaux peut avoir un nom particulier. Arriverez-vous à nommer parfaitement chacun de ces groupes d’animaux ?

Voici les 10 empereurs les plus influents de la Dynastie Han.

De nouvelles données indiquent que l’héliopause, constituant la frontière entre la bulle protectrice créée par le Soleil et le milieu interstellaire, produit des ondulations très inhabituelles.

Au début du mois d’août 1945, le Japon connaissait l’un des événements les plus violents et dévastateurs de son histoire : les bombes tombaient sur Hiroshima et Nagasaki. Dans cette vidéo, découvrez ce que ça fait de vivre un tel désastre.